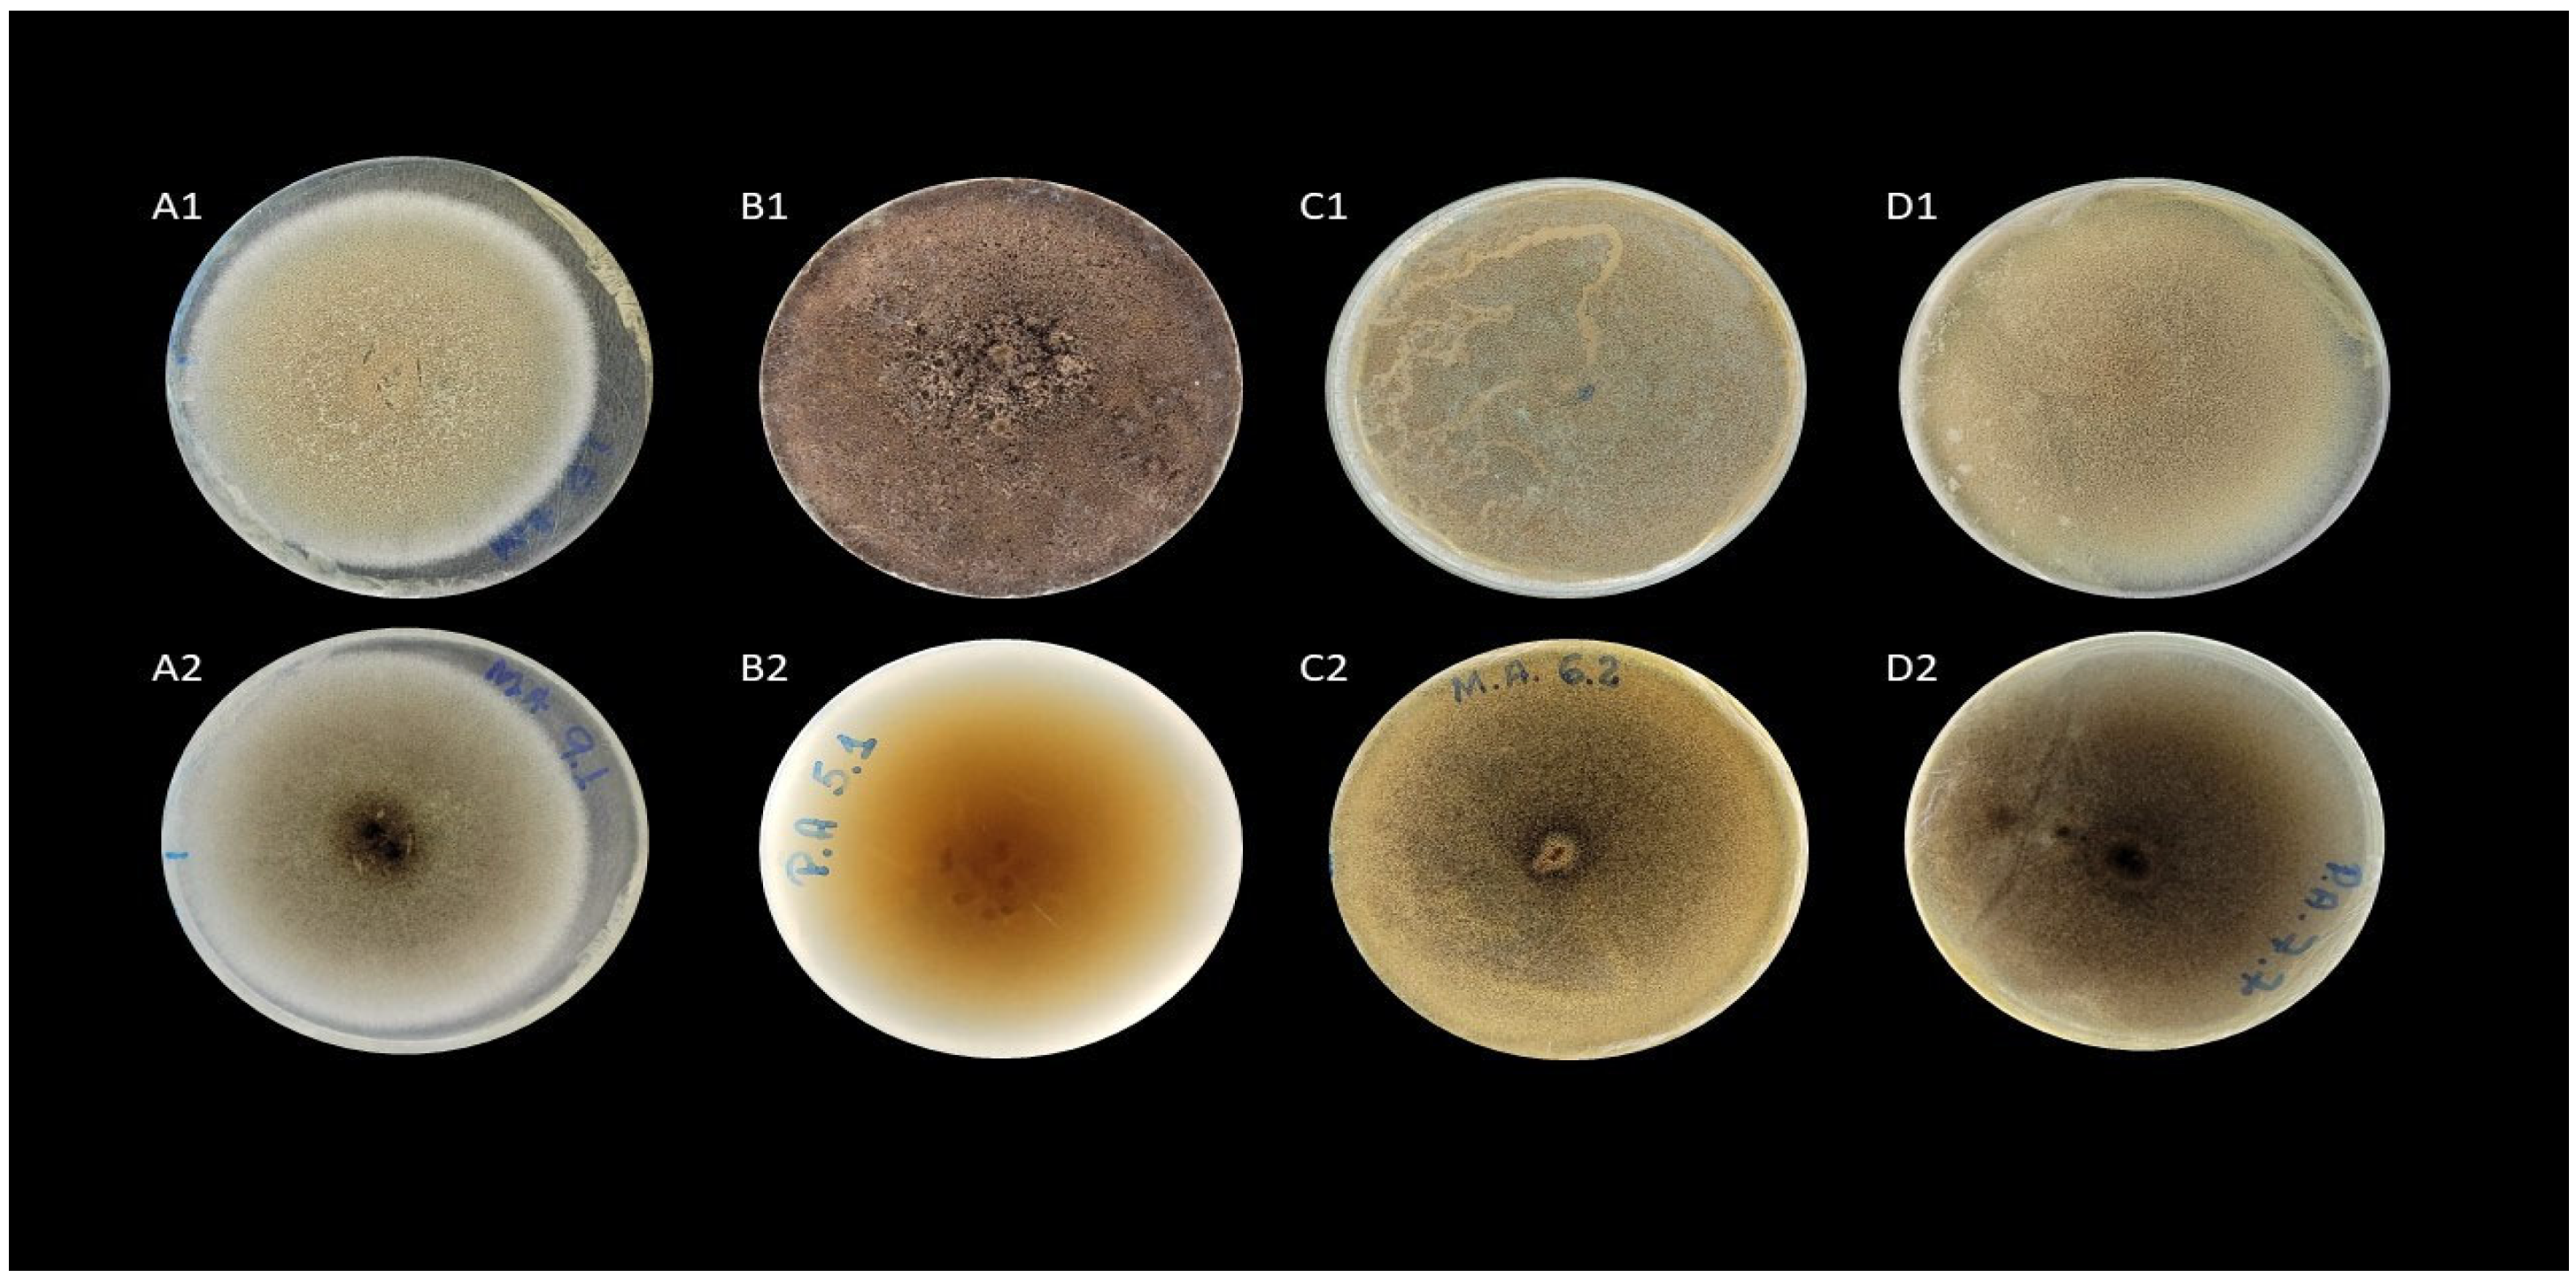
Agriculture 13 01308 g002

Prospection of Cellulolytic Fungi from Composted Samples of Saturated Horse Litter
Abstract
1. Introduction
2. Materials and Methods
2.1. Place of the Experiment, Assembly of the Piles and Obtaining the Samples
2.2. Isolation of Fungi with Cellulolytic Ability
2.3. Total Cellulase Activity
2.4. Morphological Characterization and Molecular Identification of Isolates
3. Results
3.1. Isolation of Fungi with Cellulolytic Ability
3.2. Total Cellulase Activity
3.3. Morphological Characterization and Molecular Identification of Isolates
4. Discussion
5. Conclusions
Author Contributions
Funding
Institutional Review Board Statement
Data Availability Statement
Conflicts of Interest
References
- Busato, J.G.; Paula, A.M.; Ferrari, L.H. Enriquecimento microbiano visando otimizar o processo de compostagem. In Tópicos em Ciência do Solo, 1st ed.; Severiano, E.C., Moraes, M.F., Paula, A.M., Eds.; SBCS: Viçosa, Brazil, 2019; Volume X, pp. 522–576. [Google Scholar]
- Khan, F.; Ali, Y. Moving towards a sustainable circular bio-economy in the agriculture sector of a developing country. Ecol. Econ. 2022, 196, 107402. [Google Scholar] [CrossRef]
- ONU. Organização das Nações Unidas. Objetivos de Desenvolvimento Sustentável. 2015. Available online: https://nacoesunidas.org/pos (accessed on 15 May 2022).
- De Souza, G.H.R.; Rodrigues, G.A. O tratamento da cama de equinos através do processo de compostagem. Rev. Interface Tecnológica 2017, 14, 100–110. [Google Scholar] [CrossRef]
- Böske, J.; Wirth, B.; Garlipp, F.; Mumme, J.; Van Den, W.H. Anaerobic digestion of horse dung mixed with different bedding materials in an upflow solid-state (UASS) reactor at mesophilic conditions. Bioresour. Technol. 2014, 158, 111–118. [Google Scholar] [CrossRef] [PubMed]
- Westenford, M.; Willian, C.A.; Murphy, S.; Kenny, L.; Hashemi, M. Generation and Management of Manure from Horses and Oter Equids. In Animal Manure: Production, Characteristics, Environmental Concerns, and Management; Waldrip, H.M., Pagliari, P.H., He, Z., Eds.; Inc. Soil Science Society of America: Madison, WI, USA, 2020. [Google Scholar] [CrossRef]
- Fujii, K.Y.; Dittrich, J.R.; Castro, E.A.D.; Silveira, E.O.C. Processos de tratamento de resíduos de cocheira e a redução ou eliminação de ovos e larvas infectantes do gênero Strongylus spp. Arq. Do Inst. Biológico 2014, 81, 226–231. [Google Scholar] [CrossRef]
- Greff, B.; Szigetij, J.; Nagy, A.; Lakatos, E.; Varga, L. Influence of microbial inoculants on co-composting of lignocellulosic crop residues with farm animal manure: A review. J. Environ. Manag. 2022, 302, 114088. [Google Scholar] [CrossRef]
- Harindintwali, J.D.; Zhou, J.L.; Yu, X.B. Lignocellulosic crop residue composting by cellulolytic nitrogen-fixing bacteria: A novel tool for environmental sustainability. Sci. Total Environ. 2020, 715, 136912. [Google Scholar] [CrossRef]
- Jimenez-Lopez, C.; Fraga-Corral, M.; Carpena, M.; García-Oliveira, P.; Echave, J.; Pereira, A.G.; Lourenço-Lopes, C.; Prieto, M.A.; Simal-Gandara, J. Agriculture wastes valorisation as a source of antioxidant phenolic compounds within a circular and sustainable bioeconomy. Food Funct. 2020, 11, 4853–4877. [Google Scholar] [CrossRef]
- Du, G.; Feng, W.; Cai, H.; Ma, Z.; Liu, X.; Yuan, C.; Zhang, B. Exogenous enzyme amendment accelerates maturity and changes microflora succession in horse and wildlife animal manure co-composting. Environ. Sci. Pollut. Res. 2021, 28, 1–11. [Google Scholar] [CrossRef]
- Dos Santos Pereira, T.; Paula, A.M.; Ferrari, L.H.; Silva, J.; Pinheiro, J.B.; Navas Cajamarca, S.M.; Jindo, K.; Santos, M.P.; Zandonadi, D.B.; Busato, J.G. Trichoderma-Enriched Vermicompost Extracts Reduces Nematode Biotic Stress in Tomato and Bell Pepper Crops. Agronomy 2021, 11, 1655. [Google Scholar] [CrossRef]
- Awasthi, A.K.; Yuan, Z.; Awasthi, M.K.; Li, M.; Mishra, S.; Pandey, A.K. Bioprocess potential of Eco-friendly fungal isolates converting organic waste to bioresource. Bioresour. Technol. 2022, 346, 126586. [Google Scholar] [CrossRef]
- Greff, B.; Szigeti, J.; Varga, A.; Lakatos, E.; Saho, A.; Varga, L. Effect of bacterial inoculation on co-composting of lavender (Lavandula angustifolia Mill.) waste and cattle manure. 3 Biotech 2021, 11, 306. [Google Scholar] [CrossRef]
- Sharma, P.; Gaur, V.K.; Kim, S.H.; Pandey, A. Microbial strategies for bio-transforming food waste into resources. Bioresour. Technol. 2020, 299, 122. [Google Scholar] [CrossRef]
- Xu, J.Q.; Lu, Y.Y.; Shan, G.C.; He, X.S.; Huang, J.H.; Li, Q.L. Inoculation with compost-born thermophilic complex microbial consortium induced organic matters degradation while reduced nitrogen loss during co-composting of dairy manure and sugarcane leaves. Waste Biomass Valor 2019, 10, 2467–2477. [Google Scholar] [CrossRef]
- Busato, J.G.; Ferrari, L.H.; Chagas Junior, A.F.; Silva, D.B.; Pereira, T.S.; Paula, A.M. Trichoderma strains accelerate maturation and increase available phosphorus during vermicomposting enriched with rock phosphate. J. Appl. Microbiol. 2021, 130, 1208–1216. [Google Scholar] [CrossRef]
- Wang, X.; Kong, Z.; Wang, Y.; Wang, M.; Liu, D.; Shen, Q. Insights into the functionality of fungal community during the large scale aerobic co-composting process of swine manure and rice straw. J. Environ. Manag. 2020, 270, 110958. [Google Scholar] [CrossRef]
- Wu, Y.P.; Chen, Y.X.; Shaaban, M.; Zhu, D.W.; Hu, C.X.; Chen, Z.B.; Wang, Y. Evaluation of microbial inoculants pretreatment in straw and manure co-composting process enhancement. J. Clean. Prod. 2019, 239, 118078. [Google Scholar] [CrossRef]
- Parkinson, D.T.; Gray, R.G.; Williams, S.T. Methods for studying the Ecology of Soil Microorganisms, 19th ed.; Blackwell Scientific: Melbourne, CA, USA, 1997; Volume 465. [Google Scholar]
- Tedesco, M.J.; Gianello, C.; Bissani, C.A.; Bohnen, H.; Volkweiss, S.J. Análises de Solo, Plantas e Outros Materiais. (Technical Bolletin 5), 2nd ed.; Dpto. de solos da UFRGS: Porto Alegre, Brazil, 1995; p. 174. Available online: https://rolas.cnpt.embrapa.br/arquivos/manual_rolas.pdf. (accessed on 25 May 2023).
- Ribeiro, M.C.; Soares, M.M.S.R. Microbiologia Prática: Roteiro E Manual; Atheneu: São Paulo, Brazil, 2002. [Google Scholar]
- Castellani, E.D.; Silva, A.; Barreto, M. Influência do tratamento químico na população de fungos e na germinação de sementes de Bauhinia variegata L. VAR. Variegata. Rev. Bras. De Sementes Brasília 1996, 8, 41–44. [Google Scholar] [CrossRef]
- Mandels. M.; Weber, J. Production of cellulases. Adv. Chem. Ser. Whashington 1996, 95, 391–414. [Google Scholar]
- Miller, G.L. Use of dinitrosalicylic acid reagent for determination of reducing sugar. Anal. Chem. 1959, 31, 426–428. [Google Scholar] [CrossRef]
- Ghose, T.K. Measurement of cellulase activities. Pure Appl. Chem. 1987, 59, 257–268. [Google Scholar] [CrossRef]
- White, T.J.; Bruns, T.; Lee, S.; Taylor, J. Amplifcation and Direct Sequencing of Fungal Ribosomal RNA Genes for Phylogenetics. Innis, M.A., Gelfand, D.H., Sninsky, J.J., White, T.J., Eds.; PCR Protocols: Pleasanton, CA, USA, 1990. [Google Scholar]
- Ferreira, D.F. SISVAR: A computer analysis system to fixed effects split plot type designs. Rev. Bras. Biom. 2019, 37, 529–535. Available online: http://www.biometria.ufla.br/index.php/BBJ/article/view/450> (accessed on 19 February 2023). [CrossRef]
- Sajid, S.; Kudakwashe, O.; Resco De Dios, V.; Nabi, F.; Kyung, Y.; Kaleri A., R.; Ma, L.; Zhoo, L.; Zhang, W.; Dong, F.; et al. Pretreatment of rice straw by newly isolated fungal consortium enhanced lignocellulose degradation and humification during composting. Bioresour. Technol. 2022, 354, 127. [Google Scholar] [CrossRef]
- Wang, M.; Wang, X.; Yuncheng, W.; Xiaosong, W.; Jiavin, Z.; Yu, L.; Zhe, C.; Zhongkun, J.; Wei, T.; Jibing, Z. Effects of thermophiles inoculation on the efficiency and maturity of rice straw composting. Bioresour. Technol. 2022, 354, 127–195. [Google Scholar] [CrossRef] [PubMed]
- Zeng, G.; Yu, M.; Chen, Y.; Huang, D.; Zhang, J.; Huang, H.; Yu, Z. Effects of inoculation with Phanerochaete chrysosporium at various time points on enzyme activities during agricultural waste composting. Bioresour. Technol. 2010, 101, 222–227. [Google Scholar] [CrossRef] [PubMed]
- Zhu, N.; Zhu, Y.; Kan, Z.; Li, B.; Cao, Y.; Jin, H. Effects of two-stage microbial inoculation on organic carbon turnover and fungal community succession during co-composting of cattle manure and rice straw. Bioresour. Technol. 2021, 341, 125842. [Google Scholar] [CrossRef]
- Hefnawy, M.; Gharieb, M.; Nagdi, O.M. Microbial diversity during composting cycles of rice straw. Int. J. Adv. Biol. Biomed. Res. 2019, 7, 30–43. [Google Scholar] [CrossRef]
- Noreen, N.; Ramzan, N.; Parveen, Z.; Shahzad, S. A comparative study of cow dung compost, goat pellets, poultry waste manure and plant debris for thermophilic, thermotolerant and mesophilic microflora with some new reports from Pakistan. Pak. J. Bot. 2019, 42, 1155–1159. [Google Scholar] [CrossRef]
- Danish, S.A.; Haq, T.; Paula, A.M.; Ferrari, L.H.; Silva, J.; Zafar, U. Succession and Catabolic Properties of Fungal Community During Composting of Fruit Waste at Sub-Tropical Environment Waste Biomass. Waste Biomass Valorization 2022, 13, 2017–2033. [Google Scholar] [CrossRef]
- Xu, J.Q.J.; Iang, Z.W.; Li, M.Q.; Li, Q.L. A compost-derived thermophilic microbial consortium enhances the humification process and alters the microbial diversity during composting. J. Environ. Manag. 2019, 243, 240–249. [Google Scholar] [CrossRef]
- Li, S.Y.; Li, J.J.; Yuan, J.; Li, G.X.; Zang, B.; Li, Y.Y. The influences of inoculants from municipal sludge and solid waste on compost stability, maturity and enzyme activities during chicken manure composting. Environ. Technol. 2017, 38, 1770–1778. [Google Scholar] [CrossRef]
- Rocha, V.A.L.; Maeda, N.R.; Pereira Jr, N.; Kern, F.M.; Elias, L.; Simister, R.; Mcqueen-Mason, S.J. Characterization of the cellulolytic secretome of Trichoderma harzianum during growth on sugarcane bagasse and analysis of the activity boosting effects of swollenin. Biotechnol. Prog. 2016, 32, 327–336. [Google Scholar] [CrossRef]
- Kwon-Chung, K.J.; Sugui, J.A. Aspergillus fumigatus—What makes the species a ubiquitous human fungal pathogen? PLoS Pathogens 2013, 9, 1003743. [Google Scholar] [CrossRef]
- Bilal, L.; Asaf, S.; Hamayun, M.; Gul, H.; Iqbal, A.; Ullah, I.; Lee, I.-J.; Hussain, A. Plant growth promoting endophytic fungi Asprgillus fumiga-tus TS1 and Fusarium proliferatum BRL1 produce gibberellins andregulates plant endogenous hormones. Symbiosis 2018, 76, 117–127. [Google Scholar] [CrossRef]
- Liu, D.; Li, J.; Zhao, S.; Zhang, R.; Wang, M.; Miao, Y.; Shen, Y.; Shen, Q. Secrtome diversity and quantitative analysis of cellulolytic Aspergillus fumigatus Z5 in the presence of diferente carbon sources. Biotechnol Biofuels 2013, 6, 149. [Google Scholar] [CrossRef]
- Othman, A.R.; Ismail, N.S.; Sheikh, S.R. Potential of indigenous biosurfactant-producing fungi from real crude oil sludge in total petroleum hydrocarbon degradation and its future research prospects. J. Environ. Chem. Eng. 2022, 10, 107–621. [Google Scholar] [CrossRef]
- Khyalia, P.; Dangi, J.; Barapatre, S.; Dhania, G.; Laura, J.; Nandal, M. Comparative Analysis of Compost Quality Produced from Fungal Consortia and Rice Straw by Varying C/N Ratio and its Effect on Germination of Vigna radiata. Nat. Environ. Pollut. Technol. 2022, 21, 1235–1243. [Google Scholar] [CrossRef]
- Velasco, J.; Sepulchro, A.G.V.; Higasi, P.M.; Pellegrini, V.O.; Cannella, D.; De Oliveira, L.C.; Segato, F. Light Boosts the Activity of Novel LPMO from Aspergillus fumigatus Leading to Oxidative Cleavage of Cellulose and Hemicellulose. ACS Sustain. Chem. Eng. 2022, 10, 16969–16984. [Google Scholar] [CrossRef]
- Bernardi, A.V. Identificação das Principais Enzimas Hidrolíticas de Aspergillus Fumigatus Quando Crescido em Bagaço de Cana-De-Açúcar. Master’s Thesis, Faculdade de Filosofia, Ciências e Letras de Ribeirão Preto Universidade de São Paulo, Ribeirão Preto, Brazil, 2017. [Google Scholar]

| Treatments | Average Value (UI mL−1) |
|---|---|
| MA6.2 F1 | 0.099 ± 0.03 a1 |
| MA6.2 F2 | 0.081 ± 0.05 a1 |
| MA7.9 | 0.072 ± 0.04 a1 |
| MA7.10 | 0.057 ± 0.08 a1 |
| PA5.1 | 0.376 ± 0.05 b2 |
| PA7.7 | 0.358 ± 0.06 b2 |
| PA7.10 | 0.055 ± 0.01 a1 |
| Treatments | Sequence Code | Molecular Identification |
|---|---|---|
| PA−7 7 | ITS1 01 | Aspergillus fumigatus |
| PA−7 7 | ITS4 01 | Aspergillus fumigatus |
| PA−7 5 | ITS1 02 | Aspergillus fumigatus |
| PA−7 5 | ITS1 02 | Aspergillus fumigatus |
| MA−6 2 F2 | ITS1 03 | Aspergillus fumigatus |
| MA−6 2 F2 | ITS4 03 | Aspergillus fumigatus |
| MA−7 9.1 | ITS1 04 | Aspergillus fumigatus |
| MA−7 9.1 | ITS4 04 | Aspergillus fumigatus |
Disclaimer/Publisher’s Note: The statements, opinions and data contained in all publications are solely those of the individual author(s) and contributor(s) and not of MDPI and/or the editor(s). MDPI and/or the editor(s) disclaim responsibility for any injury to people or property resulting from any ideas, methods, instructions or products referred to in the content. |
© 2023 by the authors. Licensee MDPI, Basel, Switzerland. This article is an open access article distributed under the terms and conditions of the Creative Commons Attribution (CC BY) license (https://creativecommons.org/licenses/by/4.0/).
Share and Cite
Nascimento, A.G.C.R.d.; Paula, A.M.d.; Busato, J.G.; Silva, S.G.d.; Texeira Neto, A.R. Prospection of Cellulolytic Fungi from Composted Samples of Saturated Horse Litter. Agriculture 2023, 13, 1308. https://doi.org/10.3390/agriculture13071308
Nascimento AGCRd, Paula AMd, Busato JG, Silva SGd, Texeira Neto AR. Prospection of Cellulolytic Fungi from Composted Samples of Saturated Horse Litter. Agriculture. 2023; 13(7):1308. https://doi.org/10.3390/agriculture13071308
Chicago/Turabian StyleNascimento, Ana Gabriela C. R. do, Alessandra M. de Paula, Jader G. Busato, Samia G. da Silva, and Antonio Raphael Texeira Neto. 2023. "Prospection of Cellulolytic Fungi from Composted Samples of Saturated Horse Litter" Agriculture 13, no. 7: 1308. https://doi.org/10.3390/agriculture13071308
APA StyleNascimento, A. G. C. R. d., Paula, A. M. d., Busato, J. G., Silva, S. G. d., & Texeira Neto, A. R. (2023). Prospection of Cellulolytic Fungi from Composted Samples of Saturated Horse Litter. Agriculture, 13(7), 1308. https://doi.org/10.3390/agriculture13071308

